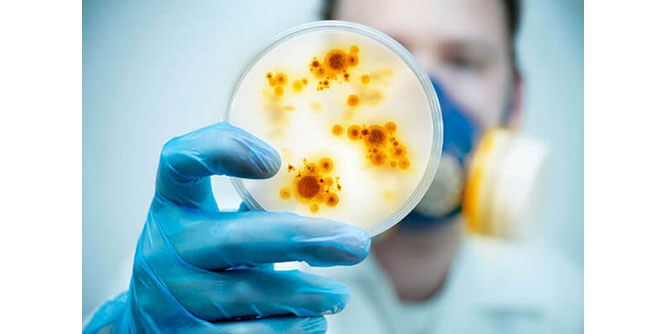
Renew Restoration Slider-5

Please Confirm
Are you sure you wish to REMOVE from your request basket?

Quick Summary
You start out in this business with an unfair head start! Quite literally on Day 1 your business will have one of the most reviews categorically, multiple awards and years of relevant experience by virtue of the online reputation the founders created. There are no ongoing fees or royalties once you are creating sales revenue. This is a true recession-proof business. Start the business as the only employee and scale to additional staff if you choose. Make 6 figures while working only 40 hours each week. No micromanagement you are truly your own boss.
*Please contact "Renew Restoration" to confirm the accuracy of any information provided on this page.
| Minimum Cash Required | $30,000 | |
| Training & Support | Yes | |
| Military/Veteran Promotion | Yes |
Indoor Air Quality / Environmental Testing and Remediation / Restoration Services
What if you could start your business tomorrow and have several consecutive years of highly rated reviews and a great online reputation on day 1 when you open your doors? wouldn't that give you a remarkable advantage over your competitors? YOU BET IT WOULD!
The ideal candidate for this business is someone who:
Potential candidates need a minimum of $30K in liquid capital. Zero sales experience? We have training for that. Don't worry - we got you!
10%
Great news! Renew Restoration has reached its current goals thanks to high demand. More franchise and business opportunities are coming soon, sign up here for updates and be the first to know! Below are a few other suggestions to start with.
Please Confirm
Are you sure you wish to REMOVE from your request basket?
We're Sorry
We only allow businesses per information request. Please complete your current requests to continue.
Oops!
Wow, glad you're interested in so many businesses! The you've inquired to will contact you shortly.
This site uses cookies. By continuing to browse the site you are agreeing to our use of cookies. Review our cookies information for more details.